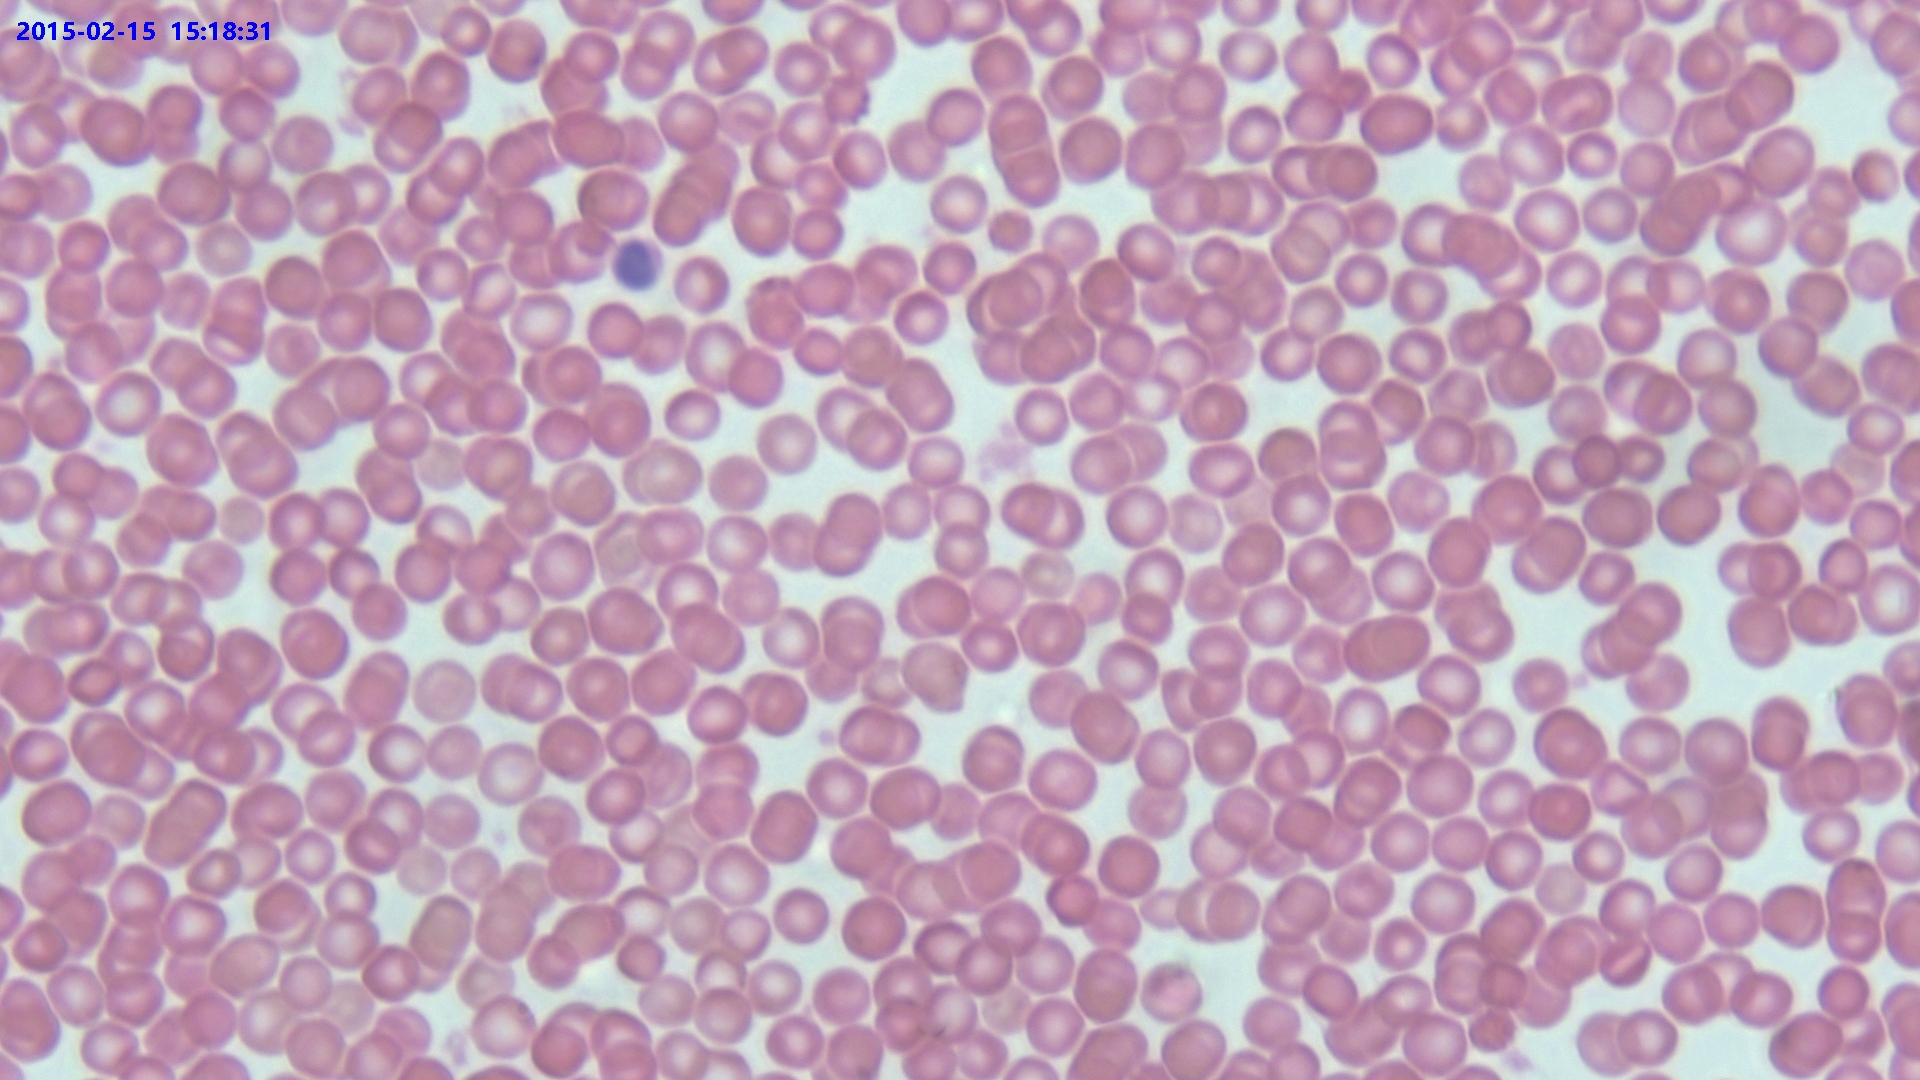

Erkennung innerer Defekte in Solarpaneelen

Kameraerkennung in der automatisierten Automobilteile-Montage
Automatisierung & Machine Vision

Pharmazeutische F&E und Komponentenerkennung

Intelligente Vision-gesteuerte Systeme in der Zellkulturerkennung
Biowissenschaften

Digitalmikroskop-Anwendungen in der Präzisionsinstrumenten-Reparatur
Bildgebungssysteme
Pathologische Präparatbeobachtung

Digitalmikroskop-Anwendungen im Heimunterricht und Hobbybereich
Biologische Bildung

Professionelle Bildgebungslösungen – Wir freuen uns auf eine Partnerschaft mit Ihnen
ToupTek Photonics verfügt über ein professionelles Technikerteam und umfangreiche Branchenerfahrung. Von der Produktberatung bis zum technischen Support bieten wir umfassende Qualitätsdienstleistungen während des gesamten Prozesses.
Beratungshotline
E-Mail-Anfrage
Unternehmensadresse
Xiyuan 5th Road Nr. 6, Bezirk Xihu,
Hangzhou, Provinz Zhejiang
Aoqiang-Gebäude 1, Etagen 13–15
